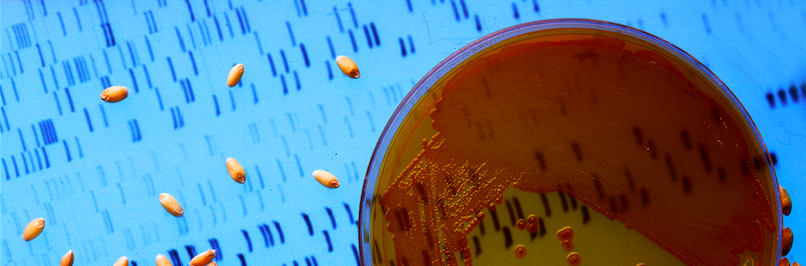

20.109(F15):DNA ligation & transformation (Day4)
Introduction
Ligation and transformation
Today you will ligate your linearized plasmid backbone with your PCR product by mixing the two in the presence of ATP and an enzyme, T4 DNA ligase. During the ligation reactions, hydrogen bonds will form between the overhangs on the fragments, and then the ligase will repair the phosphate backbone, creating a stable circular plasmid (as shown in the figure below).


If all goes well, your ligation reactions will generate your desired construct: the pCX-NXX backbone carrying the EGFP gene lacking the first 32 amino acids. You will transform this product into bacteria. During “transformation,” a single plasmid from the ligation mixture enters a single bacterium and, once inside, replicates and expresses the genes it encodes. One of the genes on the pCX-NNX plasmid leads to ampicillin-resistance. Thus, a transformed bacterium will grow on agar medium containing the antibiotic ampicillin. Untransformed cells will die before they can form a colony on the agar surface.
Most bacteria do not usually exist in a “transformation ready” state, but the bacteria can be prepared such that they are permeable to the plasmid DNA. Cells that are capable of transformation are referred to as “competent.” Competent cells are extremely fragile and should be handled gently, specifically kept cold and not vortexed. The transformation procedure is efficient enough for most lab purposes, with efficiencies as high as 109 transformed cells per microgram of DNA, but it is important to realize that even with high efficiency cells only 1 DNA molecule in about 10,000 is successfully transformed.
Protocols
Part 1: BE Communication Lab visit about abstract construction
Vivian Siegel from the BE Communication Lab will visit today to talk about writing abstracts. She will grade the abstract you submit as part of your DNA engineering summary, so be sure to take copious notes.
Part 2: Ligation reactions
For your ligation, you should use around 50-100 ng of the prepared backbone and a 1:4 molar ratio of backbone to insert. The volumes needed for these amounts can be estimated by comparison to the DNA ladder, as you saw in your homework. You will also set-up two control ligations. The “bkb + insert, no ligase” reaction controls for any errant uncut plasmid that might have wandered into your solutions. The “bkb only, plus ligase” reaction controls for religation of the backbone, from any singly cut plasmids for example.
The contents of each ligation will be
| bkb + insert, no ligase |
bkb only, plus ligase |
bkb + insert, plus ligase | |
| pCX-NNX bkb | ? μL | ? μL | ? μL |
| PCR insert | ? μL | 0 | ? μL |
| 10X Ligation Buffer^ | 1.5 μL | 1.5 μL | 1.5 μL |
| T4 DNA ligase | 0 | 0.5 μL | 0.5 μL |
| H2O | to 15 μL not including volume of enzyme | ||
^ New England Biolabs sells 10X Ligation Buffer to use with their ligase. It contains ATP so must be kept on ice.
- Assemble the reactions in eppendorf tubes, adding sequentially (1) water, (2) buffer, (3) DNA, and (4) enzymes.
- When the ligation mixtures are complete, flick the tubes to mix the contents, quick spin them in the microfuge to bring down any droplets, and then incubate the reactions at room temperature for at least 10 minutes.
Part 3: Precipitation of DNA
In this step, salts and buffers are removed from the reactions. DNA is precipitated with salt and ethanol. Yeast tRNA is added to the precipitation as “carrier,” allowing you to better visualize the DNA pellets and also likely stabilizing the DNA to improve transformation as described in this paper. The salts are washed from the pellets with 70% ethanol. The tRNA is not removed. Rather, it enters the bacteria with the ligation DNA, but is then rapidly degraded.
- Add 20 μL 3M sodium acetate to each tube.
- Add 5 μL tRNA to each tube.
- Add 200 μL 100% cold ethanol to each tube and vortex.
- Spin in a room temperature microfuge at 15,000 rpm for 15 minutes. Be sure to orient your tubes in the microfuge so you know where your pellets should be.
- You can balance your tubes with those of another group, with a water-filled eppendorf tube, or using three-way symmetry (e.g., slots 1, 9, and 17).
- When the spin is done, locate the pellets in each of the eppendorf tubes. They may appear as solid white dots at the bottom corner of the tube or they may appear to be a diffuse white smear along the wall of the tube. Both are OK. Carefully remove the ethanol from the pellets with your P1000, taking care not to disturb the pellet. You do not have to remove every last drop.
- Wash the pellets with 500 μL 70% cold ethanol. This procedure is done by dribbling the 70% ethanol along the wall of the eppendorf tube that is opposite your pellet and then removing the 70% ethanol with the same pipet tip. Again you should not disturb the pellet and you do not have to remove every drop of liquid in the tube. If the pellet seems to float away from the wall of the tube, you can re-spin the tubes for 2 minutes with the liquid to adhere the pellets to the wall again.
- Once you have washed all your pellets, give the tubes a quick spin in the microfuge to bring down any droplets of ethanol that cling to the sides of the tube then remove any remaining liquid from the tubes using your P200. Allow your tubes to dry in the hood. All the ethanol must be removed or evaporated.
Part 4: Bacterial transformations
You will perform 4 bacterial transformations, one for each of the ligation mixtures as well as one transformation with 5 ng of plasmid DNA to assess transformation frequency.
| Tube | Transformation | Add |
|---|---|---|
| 1 | positive control plasmid | 1 μL (5 ng) of pCX-EGFP |
| 2 | bkb + insert, no ligase | 5 μL |
| 3 | bkb only, plus ligase | 5 μL |
| 4 | bkb + insert, plus ligase | 5 μL |
- Resuspend the precipitated pellets from Part 2 in 15 μL sterile water by adding water to the tubes and mixing. If the DNA does not readily go into solution, it helps to heat the DNA in the 42 °C heat block, then vortex and pipet up and down several times. Bring any droplets down to the bottom of the tubes with a quick spin in the microfuge.
- Prewarm and dry five LB+AMP plates by placing them in the 37 °C incubator, media side up with the lids ajar.
- Get an aliquot of competent cells from one of the teaching faculty. Keep these cells on ice at all times. There should be at least 200 μL of cells in each tube. Aliquot 50 μL of cells into 4 clean eppendorf tubes.
- Add DNA to each tube of cells as shown in the table below.
- Flick to mix the contents and leave the tubes on ice for at least 2 minutes.
- Heat shock the cells at 42 °C for 90 seconds exactly (use your timer) and then put on ice for two minutes.
- Move the samples to a rack on your bench and use your P1000 to add 0.5 mL of LB media to each eppendorf tube. Invert each tube to mix.
- Plate 200 μL of each transformation mix on LB+AMP plates, plating the bkb + insert + ligase transformation twice. Note: After dipping the glass spreader in the ethanol jar, pass it through the flame of the alcohol burner just long enough to ignite the ethanol. After letting the ethanol burn off, the spreader may still be very hot, and it is advisable to tap it gently on a portion of the agar plate without cells in order to equilibrate it with the agar (if it sizzles, it's way too hot). Once the plates are done, wrap them together with one piece of colored tape and incubate them in the 37 °C incubator overnight. One of the teaching faculty will remove them from the incubator and set up liquid cultures for you to use next time.
Part 5: Diagnostic digest calculations
Next time you will isolate DNA from four transformants and begin to characterize the plasmids in these bacteria. Using the plasmid map you created after M1D2 and the guidelines below, plan a diagnostic restriction digest that will confirm the presence of the PCR insert. Please clearly show all your work and reasoning in your lab notebook, and be sure that your plan explicitly includes
- the enzyme names
- the buffer and temperature conditions for the reaction
- the expected band sizes for a plasmid without insert, versus the expected sizes for a plasmid with insert
- the volumes of enzyme and buffer that should be used per one 25 μL reaction containing 2.5 U of each enzyme
- the NEB website is your friend here! Mouse over tools and resources to see "popular tools"
- see also "References" on the Module 1 home page.
- you can also refer to the Day 5 protocol for a sample enzyme calculation
Diagnostic digest guidelines
When choosing enzymes for diagnostic digests, it is good practice to choose two enzymes that, together
- uniquely cut both the plasmid backbone and the insert
- verify a newly introduced restriction site on the insert
- work best in the same buffer and at the same temperature
- release fragments that can be visualized and distinguished on a gel.
- fragments smaller than 200 base-pairs may be very faint
- fragments larger than 3 kilobases are difficult to precisely size
- fragments closer together than a few hundred base-pairs may be difficult to distinguish
In an ideal world, you would run two diagnostic digests to validate your new construct, but please plan only one for the purposes of this module.
Reagents list
Ligation and precipitation
- T4 DNA Ligase Buffer (1X) from NEB
- 50 mM Tris-HCl
- 10 mM MgCl2
- 10 mM DTT
- 1 mM ATP
- 25 μg/mL BSA
- yeast tRNA
- from Life Technologies
- stock concentration is 12.5 mg/mL
Transformation
- pCX-EGFP at 5 ng/μL
- Luria-Bertani (LB) broth: Stir to dissolve, autoclave and stir to cool down:
- 1% Tryptone
- 0.5% Yeast Extract
- 1% NaCl
- 1.5% Bacto-agar
- LB+AMP plates
- LB with 2% agar and 100 μg/mL ampicillin
- XL-1 Blue E.coli (Agilent Technologies)
Navigation links
Next day: Examine candidate clones & tissue culture
Previous day: Agarose gel electrophoresis